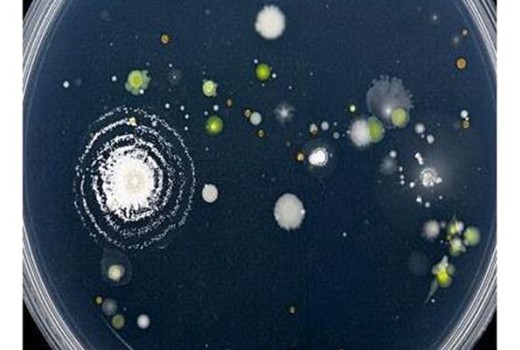
Doğal Solucan Gübresi'nin Toprak Kaynaklı Bitki Hastalıklarının Baskılanması

Rivasol® Solucan Gübresi Hakkında Merak Edilenler blog bölümünde, solucan gübresi ile ilgili güncel denemelere, kullanım alanları hakkında ayrıntılı bilgilere ulaşabilirsiniz.
RİVASOL ® BLOG İÇİN TIKLAYIN
0
26606
Kırımızı Kaliforniya Solucanları Neden Yemek Yemiyorlar ? Solucanlar yolculuk esnasında strese girerler ve bazı durumlarda bu stresten tamamen çıkmala..
4
46470
Kırmızı Kaliforniya Solucanı Nasıl Beslenir? | Rivasol ®
Evde kırmızı kaliforniya solucanı besleyerek israf olacak bitkisel atıkları değerlendirip, e..
0
51852
Kırmızı Kaliforniya Solucanları Nasıl Bakılır? Vermikompost, yiyecek artıklarını azaltarak bahçeniz için besin değeri yüksek ve zengin bir gübre meyd..
0
28681
Makedonya solucan gübresinin üretildiği ve çokça kullanıldığı bir ülke. Makedonya’da solucan gübresi kullanılan findikta 1 donumden 450-500 kg arası f..
0
26197
Ek gelir elde etmek, bir şeyler yapmak isteyen girişimci ruha sahip arkadaşlardan bazılarının solucan gübresi ve solucan üretimi işi kafalarına yatmış..
0
33405
Yükselişe Geçen Solucan Gübresi Ve Hakkında Merak EdilenlerBir çoğumuz solucanları iğrenç varlıklar olarak görürüz. Çoğu zaman onları ezdiğimizin fark..
0
29800
Çevreci Etkinliklerde Bugün: Kompost Yapıyoruz!Doğada oluşan bir çok atık, aslında başka bir işlemin ham maddesi rolündedir. Yani işlevsiz olarak nite..
0
29178
Rivasol ® Doğal Solucan Gübresi Tohum Çimlendirme Sıralarında Solucan Gübresi Kullanımı:Tohumlar çimlenen bir bitkinin hayatının ilk birkaç gününde ih..
0
29921
Charles Darwin’in en son yazdığı ve en az bilinen kitabı hiç tartışma konusu olmamıştı. 1881 yılında yayınlanan kitap, solucanların çürümüş yapraklar..
0
25536
Rivasol ® Vermikompost (solucan gübresi) ve vermikültür üretiminde, biyolojik ve ekolojik açıdan endüstriyel kullanıma en uygun solucan türü “Kırmızı ..
0
25727
Toprak Bakımında Vermikompost ÖnemiSolucan mukusu ile kaplı olan katı solucan gübresi toprağı zenginleştiren Azot, Fosfor, Potasyum gibi makro-element..
0
25883
Yeni Zelenda Topraklarının Solucan Gübresi İle Su Tutma Kapasitesi % 17 Oranında Artmıştır.Rivasol ® Vermikompost kullanılan toprakların su tutma kapa..
0
25682
Rivasol ® Kırmızı kaliforniya solucanları topraktaki yararlı mikroorganizmaların çoğalmasını sağlarken; diğer taraftan zararlı mikroorganizmaları bask..
0
26004
Solucan Gübresinin Tarım ve Toprak Üzerine Etkileri Nedir?Tarımda verimi arttırmak ve hastalıkları engellemek için kullanılan kimyasal ürünlerin topra..
0
25662
Edirne
Keşan’da bir tesis, ‘Kırmızı Kaliforniya’ adıyla bilinen solucanları organik
atıklarla besleyerek, organik gübre elde ediyor.
Keşan’da faaliyet..